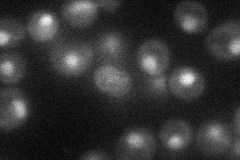
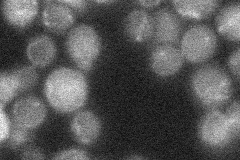
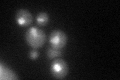
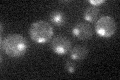

View description
NAD(+)-dependent histone deacetylase; essential subunit of the Sum1p/Rfm1p/Hst1p complex required for ORC-dependent silencing and mitotic repression; non-essential subunit of the Set3C deacetylase complex; involved in telomere maintenance
Localization:
Intensity:
Fold change:
Significance:
-
C’ GFP library in SD

nucleus22.44 -
N' NOP1pr-GFP in SD
nucleus28.1218 -
N' TEF2pr-mCherry in SD

nucleus9.90049 -
N' NATIVEpr-GFP in SD
below threshold17.9179 -
N' TEF2pr-VC and Cyto-VN in SD

below threshold21.9732 -
C’ GFP library in SD+DTT
nucleus26.721.19No -
C’ GFP library in SD+H2O2

nucleus24.771.1No -
C’ GFP library in Starvation Media
nucleus18.640.83No -
C’ GFP library on the background of Pup2-DaMP

nucleus -
C’ GFP library on the background of CCT mutant

nucleus26.54911.18268No
